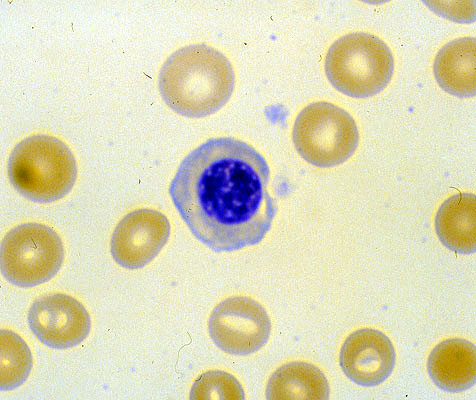

Polychromasia, peripheral blood smear
Click picture to enlarge. Close window to return
The nucleated RBC in the center of the slide shows basophilic cytoplasm and a round nucleus with densely clumped chromatin. Nucleated RBCs are not normally present in the peripheral blood.